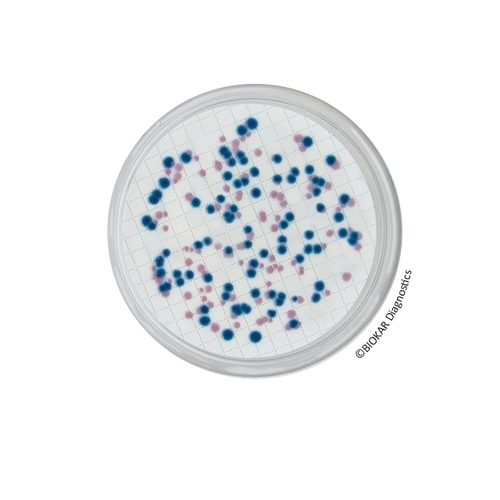
Chromogenic Coliform Agar (CCA)

Chromogenic Coliform Agar (CCA)
Chromogenic Coliform Agar (CCA) is used for the detection and enumeration of Escherichia coli and coliform bacteria in waters of low bacterial numbers (less than 100 total colonies). These waters can be drinking water, disinfected pool water or finished water from treatment plants.
| Ürün Adı | Chromogenic Coliform Agar (CCA) |
| Ürün Kodu | BK204HA |
| Miktar | 500 g |
| Ürün Adı | Chromogenic Coliform Agar (CCA) |
| Ürün Kodu | BM18208 |
| Miktar | 20 Petri plates Ø 55 mm |